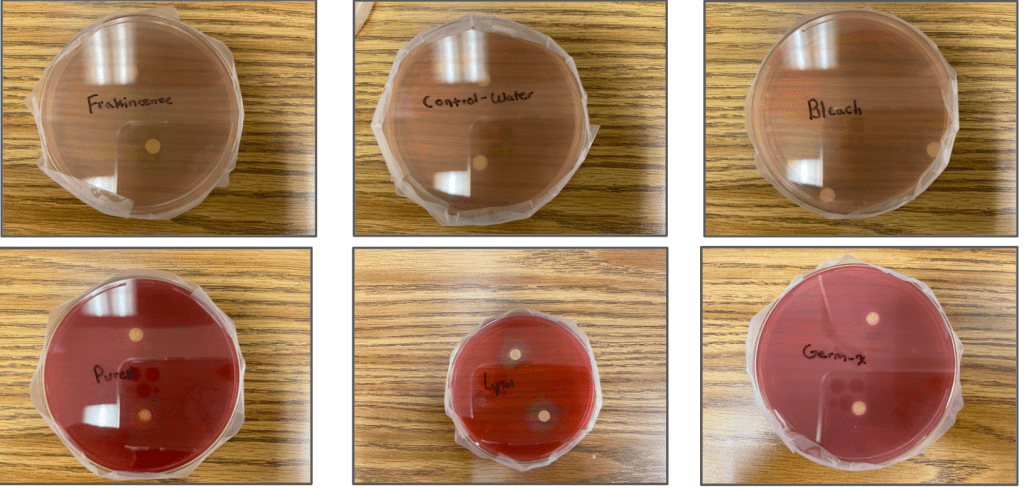

It’s time to go down memory lane! Today, I’ll be unraveling my ninth grade science project.
Since we were still in the midst of the COVID Crisis, I wanted to center my project around bacteria / germs and the best way to eliminate them. Talking with my biology teacher, she gave me a few bacteria options to choose from. Out of the options, there was Serratia Marcescens which stood out to me because of its pink / red coloration due to the pigment, prodigiosin.
Question : Which agent can effectively eliminate Serattia marcescens?
Prior to conducting my experiment, I gathered more information to expand my knowledge of bacteria, the method I would be using to test my hypothesis, and further information about the cleaning agents I would be testing.
The purpose of my project was to find out which basic household cleaning agent can kill bacteria the most effectively and sufficiently. The household agents I used in my experiment include frankincense, Lysol disinfecting spray, Germx, Purell hand sanitizer, and bleach.
With my acquiring knowledge, I formed my hypothesis. I predicted that frankincense would be the most sufficient disinfectant as it contains many organic and antiseptic properties that could kill bacteria.
Upon carrying out my experiment, I needed to come up with a plan and the method I would be using to grow my cultures. While researching, I found a disk diffusion method that tests the effectiveness of disinfectants on a specific microbe.
The first step in my experiment was to take six agar plates and spread them with Serattia marcescens. Then I took filter paper disks soaked with my selected cleaning agent(s) and placed them on top of the lawn. After two days in the incubator, the results were interpreted and data was collected. Finally, the cultures were properly disposed of to avoid creating any potential hazards.
For this experiment, I decided to test five different agents : frankincense, Lysol disinfecting spray, Germx, Purell hand sanitizer, and bleach.
To ensure that my results would be as accurate and precise as possible, I added a few procedures and precautions to the experiment. Before soaking each of my disks in the agent, I dipped the tweezers in rubbing alcohol and made sure that they were dry and sterilized to prevent any inaccurate results. In addition, to provide my experiment with a baseline that would present that my testing worked, I used sterilized water as my control group (following the same steps I did with my disinfectants).
To collect my data, I decided to let the plates sit in the incubator for two days. After two days, I measured the diameter of each inhibition zone that surrounded the disks after incubation. The inhibition was the star of the entire experiment as it indicated how effective each cleaning agent was.
When reviewing my data, the graph and tables provided an easy way for comparing all the results. Frankincense had the largest inhibition zone diameter while Germ X’s diameter had less than a centimeter.
I wish I could say my project ran perfectly, but there were a few setbacks when conducting my experiment. One of the most noticeable ones were the uneven amounts of Serratia on each plate. When carrying out this experiment, I used a pipette to try to as evenly spread the bacteria as much as possible, but in doing so, I sacrificed the amount of Serratia put on each surface.
With frankincense being organic, it was surprising that this pure oil could eliminate Serratia, a harmful pathogen that is often associated with respiratory, urinary, eye and wound infections as well as meningitis. Although all the agents were able to eliminate fragments of the microorganism, some of them proved to be not as effective.
Concluding the experiment, my hypothesis was proven to be correct. The filter paper disks soaked with frankincense developed the largest inhibition zone as well as a lighter tone of color regarding the spread out Serratia. This shows that many of the experiments and testings that I have researched are accurate as well as the many myths of essential oils being as powerful as basic household agents.
With my results demonstrating that essential oils can effectively eliminate harmful microorganisms, this could provide another solution for sufficient cleaning supplies.
In the end, all the antibiotics performed as expected, but frankincense, although an organic oil, attests to be a powerful agent.
Personally, this was one of my favorite experiments to ever conduct. Not only was it very hands on, but it aligned so perfectly with what our world was going through at the time.
Science Fair Results!
- Placed third at Districts!
- Went to State!

Leave a comment